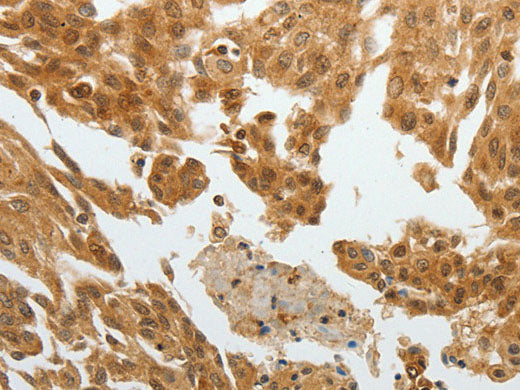
RETNLB Polyclonal Antibody Reactivity Human
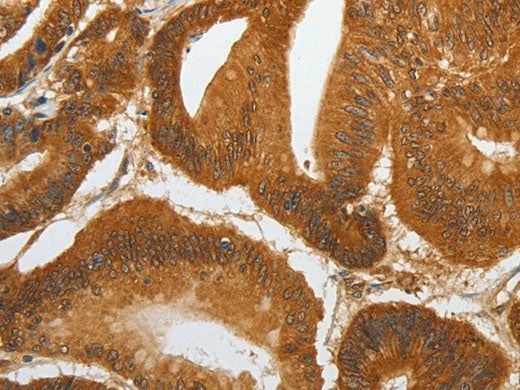
RETNLB Polyclonal Antibody Reactivity Human

RETNLB Polyclonal Antibody Reactivity Human
Couldn't load pickup availability

Still have questions? Ask our experts!
RETNLB Polyclonal Antibody Reactivity Human
| SKU # | E-AB-10579 |
| Reactivity | Human |
| Host | Rabbit |
| Applications | IHC |
Product Details
| Isotype | IgG |
| Host | Rabbit |
| Reactivity | Human |
| Applications | IHC |
| Clonality | Polyclonal |
| Immunogen | Recombinant protein of human RETNLB |
| Abbre | RETNLB |
| Synonyms | C/EBP epsilon regulated myeloid specific secreted cysteine rich protein precursor 2, CCGR, Colon and small intestine specific cysteine rich protein, Colon and small intestine-specific cysteine-rich protein, Colon carcinoma, Colon carcinoma related gene protein |
| Swissprot | |
| Cellular Localization | Secreted. |
| Concentration | 0.3 mg/mL |
| Buffer | Phosphate buffered solution, pH 7.4, containing 0.05% stabilizer and 50% glycerol. |
| Purification Method | Affinity purification |
| Research Areas | Cancer, Signal Transduction |
| Conjugation | Unconjugated |
| Storage | Store at -20°C Valid for 12 months. Avoid freeze / thaw cycles. |
| Shipping | The product is shipped with ice pack,upon receipt,store it immediately at the temperature recommended. |
Related Reagents
| Applications | Recommended Dilution |
| IHC | 1:50-1:200 |
Background
Resistin-like betais aproteinthat in humans is encoded by theRETNLBgene. An infusion of either resistin or RELMB in rats rapidly induced severe hepatic but not peripheral insulin resistance. Increases in circulating resistin or RELMB levels markedly stimulated hepatic glucose production despite the presence of fixed physiologic insulin levels. This enhanced rate of glucose output was due to increased flux through glucose-6-phosphatase. The results supported the notion that a novel family of fat- and gut-derived circulating proteins modulates hepatic insulin action.